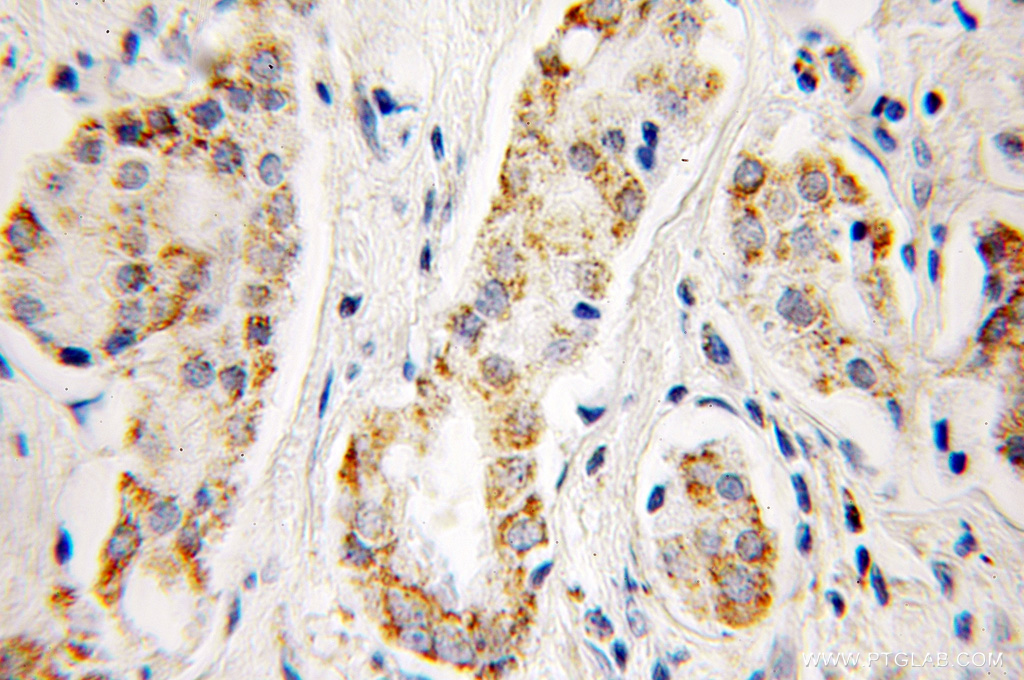

验证数据展示
经过测试的应用
| Positive WB detected in | mouse heart tissue, mouse skeletal muscle tissue, rat heart tissue, rat skeletal muscle tissue |
| Positive IHC detected in | mouse kidney tissue, human colon tissue, human lung cancer tissue, human prostate cancer tissue Note: suggested antigen retrieval with TE buffer pH 9.0; (*) Alternatively, antigen retrieval may be performed with citrate buffer pH 6.0 |
| Positive IF/ICC detected in | HeLa cells |
推荐稀释比
| 应用 | 推荐稀释比 |
|---|---|
| Western Blot (WB) | WB : 1:5000-1:50000 |
| Immunohistochemistry (IHC) | IHC : 1:200-1:1200 |
| Immunofluorescence (IF)/ICC | IF/ICC : 1:200-1:800 |
| It is recommended that this reagent should be titrated in each testing system to obtain optimal results. | |
| Sample-dependent, Check data in validation data gallery. | |
产品信息
11134-1-AP targets Aconitase 2 in WB, IHC, IF/ICC, ELISA applications and shows reactivity with human, mouse, rat samples.
| 经测试应用 | WB, IHC, IF/ICC, ELISA Application Description |
| 文献引用应用 | WB, IHC, IF |
| 经测试反应性 | human, mouse, rat |
| 文献引用反应性 | human, mouse, rat |
| 免疫原 |
CatNo: Ag1590 Product name: Recombinant human ACO2 protein Source: e coli.-derived, PGEX-4T Tag: GST Domain: 1-306 aa of BC014092 Sequence: MAPYSLLVTRLQKALGVRQYHVASVLCQRAKVAMSHFEPNEYIHYDLLEKNINIVRKRLNRPLTLSEKIVYGHLDDPASQEIERGKSYLRLRPDRVAMQDATAQMAMLQFISSGLSKVAVPSTIHCDHLIEAQVGGEKDLRRAKDINQEVYNFLATAGAKYGVGFWKPGSGIIHQIILENYAYPGVLLIGTDSHTPNGGGLGGICIGVGGADAVDVMAGIPWELKCPKVIGVKLTGSLSGWSSPKDVILKVAGILTVKGGTGAIVEYHGPGVDSISCTGMATICNMGAEIGATTSVFPYNHRMKKY 种属同源性预测 |
| 宿主/亚型 | Rabbit / IgG |
| 抗体类别 | Polyclonal |
| 产品类型 | Antibody |
| 全称 | aconitase 2, mitochondrial |
| 别名 | ACO2, ACO 2, Aconitase, Aconitase2, Citrate hydro-lyase |
| 计算分子量 | 85 kDa |
| 观测分子量 | 85 kDa |
| GenBank蛋白编号 | BC014092 |
| 基因名称 | ACO2 |
| Gene ID (NCBI) | 50 |
| RRID | AB_2289288 |
| 偶联类型 | Unconjugated |
| 形式 | Liquid |
| 纯化方式 | Antigen affinity purification |
| UNIPROT ID | Q99798 |
| 储存缓冲液 | PBS with 0.02% sodium azide and 50% glycerol, pH 7.3. |
| 储存条件 | Store at -20°C. Stable for one year after shipment. Aliquoting is unnecessary for -20oC storage. |
背景介绍
ACO2(aconitate hydratase, mitochondrial) is also named as citrate hydro-lyase and belongs to the aconitase/IPM isomerase family. It plays a key function in cellular energy production, and loss of its activity has a major impact on cellular and organismal survival. Western blot shows two bands of 83 kDa and 40 kDa. The 40 kDa fragment decreases with age and oxidative stress, whereas other fragmentation products with molecular weights between 40 and 83 kDa increased with age and MnSOD(mitochondrial manganese superoxide dismutase) deficiency(PMID:12459471). Defects in ACO2 are the cause of infantile cerebellar-retinal degeneration (ICRD).
实验方案
| Product Specific Protocols | |
|---|---|
| IF protocol for Aconitase 2 antibody 11134-1-AP | Download protocol |
| IHC protocol for Aconitase 2 antibody 11134-1-AP | Download protocol |
| WB protocol for Aconitase 2 antibody 11134-1-AP | Download protocol |
| Standard Protocols | |
|---|---|
| Click here to view our Standard Protocols |
发表文章
| Species | Application | Title |
|---|---|---|
Cell Metab Malic enzyme 2 connects the Krebs cycle intermediate fumarate to mitochondrial biogenesis. | ||
Aging Dis Dietary Salt Disrupts Tricarboxylic Acid Cycle and Induces Tau Hyperphosphorylation and Synapse Dysfunction during Aging | ||
Sci Total Environ TRIM24-DTNBP1-ATP7A mediated astrocyte cuproptosis in cognition and memory dysfunction caused by Y2O3 NPs | ||
Cell Rep A LON-ClpP Proteolytic Axis Degrades Complex I to Extinguish ROS Production in Depolarized Mitochondria. | ||
EMBO Rep UBXN1 maintains ER proteostasis and represses UPR activation by modulating translation | ||
Cell Biosci Hinokitiol-iron complex is a ferroptosis inducer to inhibit triple-negative breast tumor growth |